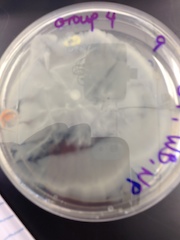
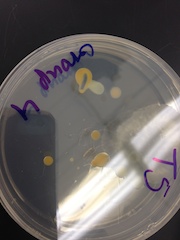

User:Wyatt Bensken/Notebook/Biology 210 at AU
Zebrafish Lab March 18, 2014
(1) Introduction:
Over the past few weeks groups of students have been observing Zebrafish development, and applying certain treatments to try to determine and examine how those treatments might alter overall development or certain aspects of Zebrafish development. My partner, Devki Gami, and I chose to use light and darkness as our two conditions in this study. We would use light as our control group, and dark as the treatment group. We would monitor the development over an extended period of time and note and significant details.
Hypothesis: Based on previous studies, we predict that Zebrafish kept in a dark environment will develop slower than those kept in normal lighting conditions.
(2) Materials and Methods:
For this experiment we started with two petri dishes, each containing twenty Zebrafish eggs. We used pipettes to ensure that the correct number of zebrafish were placed into each dish. Over time as we monitored them we would remove dead embryos as well as empty egg cases, and replace the water. For our specific treatment group we needed to have a dark place for them to develop in, and we used a drawer in the laboratory. Our control sat out with everyone else experiencing the lighting conditions in the lab. We also used a microscope and a welled-slide to observe our developing embryos. Overtime we would begin fixing samples for closer observation, and for this we used small vials, and a preservative to make sure our samples remained in good condition.
(3) Data and Observations:
Overtime we collected the following data about our Zebrafish:
(4) Conclusions:
Based on this complex data a few observations can be made:
1) Putting the Zebrafish in darkness slowed their development. This can be seen through a multitude of different factors from our data. First and foremost the delay in hatching can be seen in Day 4 between light and dark. Furthermore, we see differences in the pigmentation, and the heart rate of those kept in the dark was nearly impossible to track. Lastly, the die off rates in development show us that those exposed to less light were more successful. Unfortunately, in this experiment adding paramecium to the zebrafish slipped through the cracks and caused a major die-off for most groups, but our treatment group was able to survive longer than this point. Whether this is due to development or food consumption we may never know but the darkness seemed to play some role in delaying or preventing the death of the zebrafish embryos.
2) Movement is related to light exposure. We noticed from week to week (up until the last two days of observation) that the dark zebrafish were a lot less motile at first, but as they were exposed to the light of the microscope and other light they began moving around more and more. Now, it's hard to draw a consistent trend from the data we collected because of the additional factor of food consumption, but light exposure did appear to play a role in the movement.
and finally
3) There are certain aspects of the Zebrafish that despite the difference in lighting remain the same. For example, the twitching of the fins in the last week was clearly evident in both the light and dark zebrafish. While we saw that light exposure played a major role in many factors of development, some aspects remained consistent between the control and treatment.
Overall this experiment did in fact prove our hypothesis, by showing that lighting plays a relatively significant role in the development of Zebrafish.
Lab 5/6 February 20, 2014 2/21/14
(1) Introduction: Invertebrates + Embryology & Zebrafish Development
For this particular lab we had to not only make up our Invertebrates lab, but we had to complete the Embryology lab and Zebrafish lab. First, for the invertebrates lab we looked at the specimens that our Berlese funnel had presented us. Then for the Embryology lab we began to explore embryology and prepared out Zebrafish for the coming weeks.
(2) Materials and Methods:
For the invertebrates we simply took the samples from out tube and observed them. We, unfortunately, only had one and we identified it as a flea. Once we had identified we reported over the station with samples and began to identify key characteristics of: Arachnids, Crustaceans, Millipedes, Centipedes, and Insects. This worksheet and these samples were to get us thinking about the samples and specific characteristics of these invertebrates. After we identified these, we moved on to observe round worms and flat worms. All of this was to help us get a better grasp invertebrates and recognize specific and unique features.
For the Zebrafish lab we talked through our individual reports we read and then began to explore the topic of embryology. During the embryology discusion we had the opportunity to explore frog and chicken embryos. By exploring these we are getting hands on experience observing topics we've talked about in lecture and lab. We then proceeded to prepare our samples for Zebrafish which for us was to prepare two samples of 20 Zebrafish each. Once we had placed 20 each into petri dishes with 20mls of water, we placed one in light and one in darkness, and will check in on Monday to see how they have developed since Thursday. We chose to look at the development of the retina and how that could effect the zebrafish down the road.
(4) Conclusion:
A lot of this particular lab involved a lot of observing and noting how particular things appeared. While we had a small hands-on time with invertebrates and identifying them, this lab was mainly covering information to prepare us for upcoming labs.
Furthermore, for the Invertebrates lab we were asked to construct a food-web of our transect. Our transect was rather unique and thus is fairly difficult to construct a food web for. Our transect is the community gardens, which is a fenced in area, used by student to grow plants in the spring and fall. What makes our transect hard to create a food web for is the fact that it is fenced in and closed off from everything around it. It is a very controlled environment therefore the only things we found were leaf litter and decaying plants. We expected to find very small invertebrates in this leaf litter but to our surprise our Berelese funnel only gave us one. Additionally, a lot of the soil is brought in to help the plants in the beds flourish. It's because of this strictly controlled and isolated environment that we cannot make a factual and accurate food web for.
Lab 4 February 6, 2014 2/10/14
(1) Introduction: Plantae and Fungi
The purpose of this particular lab was to explore our transects for different types of plants, and to explore the different aspects of a plant and it's development. Additionally we set up our Berlese Funnel. Furthermore, we started the lab by exploring the PCR reactions and conducting a run.
(2) Materials and Methods:
For this particular lab we needed three bags, a camera (optional but we used our phones) to collect samples from our transects. Once we had collected our leaf sample we took a mixture of dead leaves and soil to set up our Berlese funnel.
Back in the lab we took a look at our plants, then set up our Berlese. To do this we followed these steps:
- Pour about 25 ml of the 50:50 ethanol/water solution into the flask or bottle.
- Fit a piece of the screening material into the bottom of the funnel. Tape the sides of the screen if necessary, so that the leaf litter does not fall into the preservative.
- Place the funnel into the neck of the square-sided bottle.
(3) Data and Observations:
Describe the five plants and where they were found in your notebook:
- We found most of our leaves in the garden beds in the transect, because that's where most of the vegetation was. [insert pictures!]
- We concluded the following:
- Sample 1: this was not from a tree, and appeared to be a simple heart tooth shape
- Sample 2: Clover leaf
- Sample 3: Sage
- Sample 4: Another type of clover
- Sample 5: This leaf looked incredibly similar to the western cedar
Other details we concluded were that all of our plants appeared to be vascular. Unfortunately, our transect didn't show much evidence of flowers or other reproductive parts because of the nature of the transect.
(4) Conclusion:
This Lab helped us look at prepared examples, then apply that knowledge to the sample we collected from our transect. What I learned from this lab was that most of what is around our transect is not natural: it has been planted. Additionally, because of this it has been protected from outside elements but noone has been around to take care of the plants. These facts mean that in essence our transect is dead. However, it will be interesting to see how it continues to grow throughout the semester.
Lab 3 January 30, 2014
(1) Introduction: Bacteria, Stains, and PCR
This week's lab was focused on exploring the bacteria we cultured last week and preparing our samples for PCR. First we retrieved our original jars and observed what they looked like. Our jar settled even more and did not look as dirty as it did after one week, additionally the odor was not as sever as it was after one week.
(2) Materials and Methods:
Quantification of the colonies
- we tried to calculate the colonies/ml but because our samples were not ideal the calculations could not help us arrive at a number of colonies/ml
Antibiotic Resistance
- first we took samples from specific parts of our slide and observed them under our microscope
- we had to use oil on the 100x to get a clear of our bacteria
- gram staining procedure:
1. Label the slides. 2. Heat fix the air dried slide by passing it through a flame three times with the bacterial smear side up! 3. Working with a staining tray, cover the smear with crystal violet for 1 minute. 4. Rinse the stain off using a wash bottle filled with water. 5. Cover the smear with Gram's iodine mordant for 1 minute. Rinse gently. 6. Decolorize by flooding the smear with 95% alcohol for 10-20 seconds. Rinse gently. Decolorization has occurred when the solvent flows colorlessly from the slide! 7. Cover the smear with safranin stain for 20-30 seconds. Rinse gently. 8. Blot excess water carefully with a paper towel and air dry. 9. After the gram stain is done, focus in on the sample at a low magnification, then observe the slide under 40X and the oil objective. (coverslips are not used with gram stains).
PCR
- we prepared our samples for genetic sequencing
- we followed the directions presented in the lab
(3) Data and Observations:
Our two samples looked like:
Table:
Questions:
- Explain why the appearance or smell might change week to week? With our particular sample we noticed that it settled quite a significant amount more, that plus some water evaporation, and the fact we shook it last time meant there wasn't that much growth on it.
- Do you see any differences in the colony types between the plates with vs without antibiotic? What does this indicate? Yes! The plates without antibiotics have a large amount compared to the plates with it. This meant that the antibiotics prevented some types from growing.
- What is the effect of tetracycline on the total number of bacteria? Fungi? It decreased the total number.
- How many species of bacteria are unaffected by tetracycline? What does tetracycline impact? According to Microbiology and Molecular Biology Review: "including gram-positive and gram-negative bacteria, chlamydiae, mycoplasmas, rickettsiae, and protozoan parasites." It is very broad range, but there are some types of bacteria that have become resistant "resistance now occurs in an increasing number of pathogenic, opportunistic, and commensal bacteria".
Lab 2 January 23, 2014
(1) Introduction: Dichotomous Key, Hay Infusion, and Serial Dilution
The purpose of this experiment was to gain experience using a dichotomous key, practicing identification using our Hay Infusion samples and preparing serial dilutions for next weeks lab.
(2) Materials and Methods:
Dichotomous Key:
- obtain key
- make a wet mount of a sample from the provided jar and using ProtoSlo
- locate an organism, draw and identify
- repeat
Hay Infusion:
- observe, without disturbing, the hay infusion jar
- take a few samples from different niches (top and bottom)
- make a wet mount, use Protoslo and observe organisms
- identify organisms
Serial Dilutions:
- obtain 4 tubes of 10mls sterile broth and label 2, 4, 6, 8
- obtain micropipeter set at 100 microliters
- obtain four nutrient agar and four agar plus tetracycline plates and label one plate from each group 10^-3, 10^-5, 10^-7, 10^-9
- mix hay infusion culture
- take 100 microliters from the mix and add to the 10mls of broth in the tube labeled 2 to create a 1:100 dilution
- take 100 microliters from the #2 tube and add to the #4 tube to creat a dilution of 1:10,000
- repeat for tubes 6 and 8
- take 100 microliters from the #2 tube and spread it on the nutrient agar plate 10^-3
- repeat the same for the tetracycline plate
- repeat this with #4 tube on the 10^-5 plate, #6 on the 10^-7, and #8 on the 10^-9
(3) Data and Observations:
When we retrieved our Hay Infusion we noticed the following about it:
- Smell: wet, moss, very sour
- Appearance: water was cloudy, there appeared to be some silt/sand settled at the bottom, there was a layer at the top of some sort of slime or mold.
Niches
1) The silt on the bottom 2) The slime layer along the top
Organisms:
We observed the following organisms from our niches:
Bottom: Hypotrich (~150 micrometers), and other very small motile organisms, there were no other identifiable organisms. Top: Chilomonas, Paramecium, and other small motile organisms.
(4) Conclusion:
Questions:
How this species meets requirements for life? Paramecium has evolved over time is single celled and it uses energy it obtains form food.
If we were to observe for another two months what changes would we expect to occur? I would say that the major changes we would see is that there would be more growth of the mold and slime and possibly to see more organisms.
What selective pressures affected the composition of your sample? I would say for this sample it was mainly the environment. Our sample came from an area of garden plots which was fenced in so it limited the amount of organisms that could be carried in by animals or other forces. WB ---
Lab 1 January 16, 2013
(1) Introduction: Understanding Natural Selection and identifying our Transects
The purpose of this experiment was to get us to visualize the effects of natural selection, and to observe our transects for the first time.
(2) Materials and Methods:
Volvicine Line:
- prepare of slide of Chlamydomonas
- add Protoslo
- identify a sample, draw and measure it
- prepare slides of Gonium and Volvox
- observe and measure
Transects:
- locate transects
- identify key features
- take a sample using a 50ml conical tube
Make a hay infusion:
- weigh 10-12 grams of soil/ground sample and place in jar with 500mls of deerpark water
- add .1gms dried milk and gently mix for 10 seconds
- keep lid off and place it safely in the lab
(3) Data and Observations:
Image of drawing of the organisms Image of map of transect
Biotic items in transect: tomato, cabbage, unidentified green leafy plants, wood, sage Abiotic items in transect: soil, stone, nails, paint, tennis ball, plastic bag
(4) Conclusion:
It is important to monitor the transect throughout the semester and watch for any changes in the environment around it.
Very good start. Don't need to rewrite lots of text from protocol, put into own words. SK